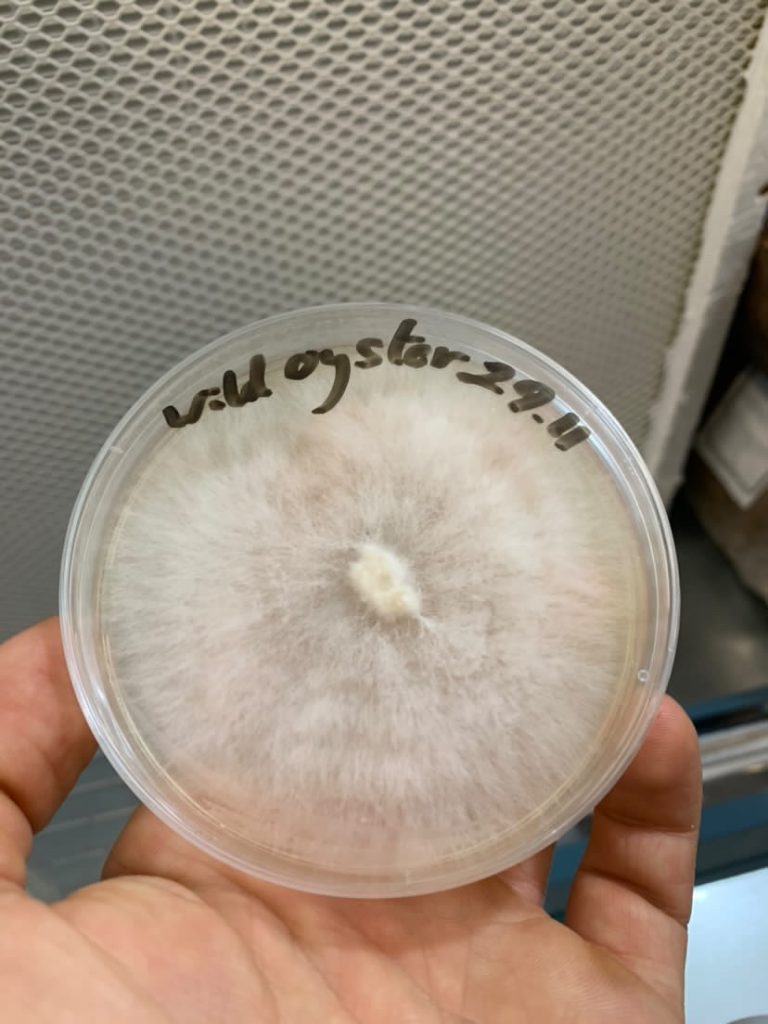

Filter

MEDLAR STICKY TOFFEE PUDDING aka “TUDOR-ARSE FRUIT” Medlar (Mespilus germanica)
MEDLAR STICKY TOFFEE PUDDING aka “TUDOR-ARSE FRUIT” Medlar (Mespilus germanica)

“King Alfred’s Cakes” aka Cramp Balls, Coal Fungus, Carbon Fungus (Daldinia Concentrica).
“King Alfred’s Cakes” aka Cramp Balls, Coal Fungus, Carbon Fungus (Daldinia Concentrica).

Birch Polypore (Fomitopsis betulina)
Birch Polypore (Fomitopsis betulina)

Honey Fungus aka Bootlace Fungus (Armillaria mellea)
Honey Fungus aka Bootlace Fungus (Armillaria mellea)

Charcoal Burner (Russula cyanoxantha)
Charcoal Burner (Russula cyanoxantha)

WILD LIONS MANE (Hericium erinaceus)
WILD LIONS MANE (Hericium erinaceus)

SPOOKY ALBINO WEREWOLF MUSHROOM
SPOOKY ALBINO WEREWOLF MUSHROOM

🍄🍄 FLY AGARIC 🍄🍄
🍄🍄 FLY AGARIC 🍄🍄

Panther Cap (Amanita pantherina)
Panther Cap (Amanita pantherina)

Porcelain Fungus (Oudemansiella mucida / Mucidula mucida)
Porcelain Fungus (Oudemansiella mucida / Mucidula mucida)

Brown Roll Rim (Paxillus involutus)
Brown Roll Rim (Paxillus involutus)

Autumn – 1 day in the woods
Autumn – 1 day in the woods

Violet Webcap (Cortinarius violaeus)
Violet Webcap (Cortinarius violaeus)

PESTLE PUFFBALL (Lycoperdon excipuliforme)
PESTLE PUFFBALL (Lycoperdon excipuliforme)

Yarrow (Achillea millefolium)
Yarrow (Achillea millefolium)
Mugwort (& Thujone) (Artemisia vulgaris)
Mugwort (& Thujone) (Artemisia vulgaris)

STUFFED & BAKED CEP
STUFFED & BAKED CEP

BEEFSTEAK MUSHROOM LASAGNA
BEEFSTEAK MUSHROOM LASAGNA

Pan-Fried Cauliflower Fungus & Chicken of the Woods on Toast
Pan-Fried Cauliflower Fungus & Chicken of the Woods on Toast

BLACKBERRY & LADIES BEDSTRAW COUNTRY WINE
BLACKBERRY & LADIES BEDSTRAW COUNTRY WINE

Brewing History, Gruit Herb, Witches and Ergot
Brewing History, Gruit Herb, Witches and Ergot

RUSSULA SPOTTING BRITTLEGILLS – The Beechwood Sickener
RUSSULA SPOTTING BRITTLEGILLS – The Beechwood Sickener

Dotted Stem Bolete / Scarletina Bolete
Dotted Stem Bolete / Scarletina Bolete

Stinkhorn mushroom – Witches Egg Stage
Stinkhorn mushroom – Witches Egg Stage

Celerbration of the Plum
Celerbration of the Plum

The 3 CEPs
The 3 CEPs

BEEFSTEAK FUNGUS aka OX TONGUE FUNGUS
BEEFSTEAK FUNGUS aka OX TONGUE FUNGUS

SPEED FORAGING – APPLE & BLACKBERRY CRUMBLE
SPEED FORAGING – APPLE & BLACKBERRY CRUMBLE

PENNY BUN / PORCINI / CEP / STEINPILZ / KING BOLETE
(Boletus Edulis)
PENNY BUN / PORCINI / CEP / STEINPILZ / KING BOLETE (Boletus Edulis)

THE YEW TREE (Taxus baccata)
THE YEW TREE (Taxus baccata)

COMMON EARTHBALL
(Scleroderma citrinum)
COMMON EARTHBALL (Scleroderma citrinum)

Silky Rosegill (Volvariella Bombycina)
Silky Rosegill (Volvariella Bombycina)

The Blusher (Amanita Rubescens)
The Blusher (Amanita Rubescens)

Linden / Lime Tree “Chocolate” (Tillia Cordata)
Linden / Lime Tree “Chocolate” (Tillia Cordata)

Wild marjoram / Oregano (Origanum vulgare)
Wild marjoram / Oregano (Origanum vulgare)

Water Pepper aka arse smart (Persicaria hydropiper)
Water Pepper aka arse smart (Persicaria hydropiper)

Black Mulberry (Morus nigra)
Black Mulberry (Morus nigra)

The Foxglove (Digitalis purpurpea)
The Foxglove (Digitalis purpurpea)

Sun-Dried Wood Ear Fungus (Auricularia auricula-judae)
Sun-Dried Wood Ear Fungus (Auricularia auricula-judae)

St John’s Wort (Hypericum perforatum)
St John’s Wort (Hypericum perforatum)

Summer Oyster Mushroom aka Pale Oyster (Pleurotus pulmonarius)
Summer Oyster Mushroom aka Pale Oyster (Pleurotus pulmonarius)

HEDGEROW NATURAL SODA
HEDGEROW NATURAL SODA

SEA KALE KRAUT (Crambe Maritima)
SEA KALE KRAUT (Crambe Maritima)

CLOSED LOOP RYE SEEDED SOURDOUGH
CLOSED LOOP RYE SEEDED SOURDOUGH

Wild Garlic Caviar / Capers (Allium Ursinum)
Wild Garlic Caviar / Capers (Allium Ursinum)

BLACK CHERRY PLUMS
BLACK CHERRY PLUMS

SALTED SAKURA CHERRY BLOSSOMS & WILD PLUM UMEZU
SALTED SAKURA CHERRY BLOSSOMS & WILD PLUM UMEZU

MUSHROOM KEBAB
MUSHROOM KEBAB

MUSHROOM COOKING METHODS
MUSHROOM COOKING METHODS

FERMENTING GREEN PINE CONES
FERMENTING GREEN PINE CONES

3 Cornered Leek & Carlin Pea Miso
3 Cornered Leek & Carlin Pea Miso

Nettle “Matcha”
Nettle “Matcha”

PICKLING MUSHROOMS & OTHER ELEMENTS
PICKLING MUSHROOMS & OTHER ELEMENTS

The Pantry
The Pantry

Bay Leaf, Rhubarb & Gorse “Cheong”
Bay Leaf, Rhubarb & Gorse “Cheong”

Tree Mallow “Molokhia”
Tree Mallow “Molokhia”

Tree Mallow Dolma w Wild Leaf Cacık
Tree Mallow Dolma w Wild Leaf Cacık

NETTLE SEED PITA
NETTLE SEED PITA

WILD GARLIC RISKS
WILD GARLIC RISKS

TURNIP CAKE 4.0
TURNIP CAKE 4.0

THREE-CORNERED LEEK 🌱 (Allium triquetrum)
THREE-CORNERED LEEK 🌱 (Allium triquetrum)

NOODLES, WOOD EAR, THREE CORNERED LEEK, FERMENTED CHILLI, SLOE VINEGAR
NOODLES, WOOD EAR, THREE CORNERED LEEK, FERMENTED CHILLI, SLOE VINEGAR

USING WILD GARLIC BRINE & BURNT 3 CORNERED LEEK OIL
USING WILD GARLIC BRINE & BURNT 3 CORNERED LEEK OIL

COOKING WITH WILD INGREDIENTS – WOOD EAR
COOKING WITH WILD INGREDIENTS – WOOD EAR

🎄🍄🟫CHRISTMAS FUNGUS & WINTER GREENS🥬 🍄🟫
🎄🍄🟫CHRISTMAS FUNGUS & WINTER GREENS🥬 🍄🟫

FLY AGARIC (Amanita Muscaria)
FLY AGARIC (Amanita Muscaria)

Winter Chanterelle (Cantherellus tubaeformis)
Winter Chanterelle (Cantherellus tubaeformis)

Trompette de la Mort / Black Trompette / Horn of Plenty ((Craterellus cornucopioides)
Trompette de la Mort / Black Trompette / Horn of Plenty ((Craterellus cornucopioides)

Elderberry Mead
Elderberry Mead

WINTER CHANTERELLE, SWEET CHESTNUT, PUMPKIN & CRISPY SAGE GNOCHHI PT2
WINTER CHANTERELLE, SWEET CHESTNUT, PUMPKIN & CRISPY SAGE GNOCHHI PT2

WINTER CHANTERELLE, SWEET CHESTNUT, PUMPKIN & CRISPY SAGE GNOCHHI PT1
WINTER CHANTERELLE, SWEET CHESTNUT, PUMPKIN & CRISPY SAGE GNOCHHI PT1

CRISPY FRIED CORAL TOOTH FUNGUS WITH ELDERBERRY HOT SAUCE/MAYO
CRISPY FRIED CORAL TOOTH FUNGUS WITH ELDERBERRY HOT SAUCE/MAYO

Wild Mushrooms on Toast
Wild Mushrooms on Toast

Hedgehog fungus (Hydnum repandum)
Hedgehog fungus (Hydnum repandum)

🍄FLY AGARIC (Amanita muscaria)🍄 – Growth Cycle and Potential Risks
🍄FLY AGARIC (Amanita muscaria)🍄 – Growth Cycle and Potential Risks

Horn of plenty 🇬🇧 Black trumpet 🇺🇸 Trompette de la mort 🇫🇷 (Craterellus cornucopioides)
Horn of plenty 🇬🇧 Black trumpet 🇺🇸 Trompette de la mort 🇫🇷 (Craterellus cornucopioides)

The Deathcap
The Deathcap

Hedge garlic / Jack-by-the-hedge (Alliaria petiolata) Cabbage Family
Hedge garlic / Jack-by-the-hedge (Alliaria petiolata) Cabbage Family

Chicken of the Woods Katsu with Wild Spices
Chicken of the Woods Katsu with Wild Spices

Sunflower Seed Tahini
Sunflower Seed Tahini

Damson Preserve Recipes
Damson Preserve Recipes

Flavour Fred x Ferm London
Flavour Fred x Ferm London

Shroom Spheres
Shroom Spheres

Pickled Blackberries
Pickled Blackberries

Cinnabar Caterpillar
Cinnabar Caterpillar

Samphire, toasted caraway, kohlrabi & fennel sauerkraut
Samphire, toasted caraway, kohlrabi & fennel sauerkraut

Beech Leaf Noyau Update
Beech Leaf Noyau Update

🌱Water Pepper aka arse smart🌱
🌱Water Pepper aka arse smart🌱

Roast Vegan Chicken of the Woods
Roast Vegan Chicken of the Woods

Foxglove (Digitalis purpurpea)
Foxglove (Digitalis purpurpea)

Sea Kale (Crambe Maritima)
Sea Kale (Crambe Maritima)

Common Mallow (Malva sylvestris)
Common Mallow (Malva sylvestris)

Wood Sorrel (Oxalis acetosella)
Wood Sorrel (Oxalis acetosella)

GREEN ELF CUP
GREEN ELF CUP

PINEAPPLE WEED & ELDERFLOWER TEPACHE
PINEAPPLE WEED & ELDERFLOWER TEPACHE

Japanese Knotweed (Reynoutria japonica / Fallopia japonica)
Japanese Knotweed (Reynoutria japonica / Fallopia japonica)

SWEET WOODRUFF (Gallium odoratum)
SWEET WOODRUFF (Gallium odoratum)

BEECH LEAF NOYAU
BEECH LEAF NOYAU

ELDERFLOWER PICKING RISKS
ELDERFLOWER PICKING RISKS

🐺WOLFSBANE 🐺 aka Monkshood (Aconitum napellus)
🐺WOLFSBANE 🐺 aka Monkshood (Aconitum napellus)

Cuckoo Flower / Ladies Smock (Cardamine pratensis)
Cuckoo Flower / Ladies Smock (Cardamine pratensis)

Common Dandelion *2023 video refresh
Common Dandelion *2023 video refresh

Fermented Hot Sauce
Fermented Hot Sauce

CLONED NATIVE OYSTER MUSHROOM PART 2
CLONED NATIVE OYSTER MUSHROOM PART 2

Wild Garlic (Allium Ursinum) Picking Risks
Wild Garlic (Allium Ursinum) Picking Risks

SMOKEY, CHARRED, FERMENTED OYSTER MUSHROOM, WILD GARLIC, 3-CORNERED LEEK & MISO BURGERS
SMOKEY, CHARRED, FERMENTED OYSTER MUSHROOM, WILD GARLIC, 3-CORNERED LEEK & MISO BURGERS

Winter chanterelle flatbreads with parasol mushroom butter
Winter chanterelle flatbreads with parasol mushroom butter

🌲 DOUGLAS FIR 🌲
🌲 DOUGLAS FIR 🌲

SCARLET / RUBY ELFCUP
SCARLET / RUBY ELFCUP

SAFE IDENTIFICATION – Cow parsley versus Poison Hemlock
SAFE IDENTIFICATION – Cow parsley versus Poison Hemlock

(MISO-MARINATED) LIONS MANE
(MISO-MARINATED) LIONS MANE
BIO-PROSPECTING – CLONING LOCAL OYSTER MUSHROOMS
BIO-PROSPECTING – CLONING LOCAL OYSTER MUSHROOMS

GIFTS CREATED FROM CHRISTMAS CONIFERS
GIFTS CREATED FROM CHRISTMAS CONIFERS

TRUFFLE TOPPING TREAT ON MUSHROOM MEDLEY
TRUFFLE TOPPING TREAT ON MUSHROOM MEDLEY

Wood Blewit (Lepista nuda)
Wood Blewit (Lepista nuda)

Magpie Inkcap (Coprinopsis picacea)
Magpie Inkcap (Coprinopsis picacea)

Young Fly Agaric vs Common Puffball
Young Fly Agaric vs Common Puffball

Sweet Chestnut & Boozy Berry Compote
Sweet Chestnut & Boozy Berry Compote

Roasted Sweet Chestnut & Celeriac Soup
Roasted Sweet Chestnut & Celeriac Soup

Shaggy Inkcap (Coprinus comatus)
Shaggy Inkcap (Coprinus comatus)

Orange Oak Bolete
Orange Oak Bolete

Beefsteak, Ecology, Responsibility
Beefsteak, Ecology, Responsibility

CEP TAKEOVER
CEP TAKEOVER

Brown Birch Bolete (Leccinum scabrum)
Brown Birch Bolete (Leccinum scabrum)

PARASOL SCHNITZEL with potato & oak leaf gherkin salad
PARASOL SCHNITZEL with potato & oak leaf gherkin salad

🌱 FERMENTED WILD GARLIC FLATBREAD🌱
🌱 FERMENTED WILD GARLIC FLATBREAD🌱

Parasitic Bolete (Pseudoboletus parasiticus)
Parasitic Bolete (Pseudoboletus parasiticus)

👌🏻Fermented Blackberry & Fire Cider Vinegar Fruit Leather👌🏻
👌🏻Fermented Blackberry & Fire Cider Vinegar Fruit Leather👌🏻

Witches Egg -> Stinkhorn mushroom (Phallus Impedicus)
Witches Egg -> Stinkhorn mushroom (Phallus Impedicus)

Girolle & Brown Birch Bolete Bhaji
Girolle & Brown Birch Bolete Bhaji

Damson & Fermented Blackberry Chutney
Damson & Fermented Blackberry Chutney

Girolles / Chanterelle (Cantharellus cibarius)
Girolles / Chanterelle (Cantharellus cibarius)

Porcini Poutine
Porcini Poutine

🌱Water Pepper aka arse smart🌱 (Persicaria hydropiper)
🌱Water Pepper aka arse smart🌱 (Persicaria hydropiper)

Meadowsweet AKA Queen of the Meadow, Meadsweet or Mead Wort (Filipendula ulmaria)
Meadowsweet AKA Queen of the Meadow, Meadsweet or Mead Wort (Filipendula ulmaria)

Common Mallow (Malva sylvestris)
Common Mallow (Malva sylvestris)

🐛🌼Cinnabar Caterpillar🌼🐛
🐛🌼Cinnabar Caterpillar🌼🐛

🙏🚶👌🏻RUSSULA SPOTTING👌🏻🚶🙏 THE BRITTLEGILLS
🙏🚶👌🏻RUSSULA SPOTTING👌🏻🚶🙏 THE BRITTLEGILLS

🍹FULL YEAR NEGRONI🍹
🍹FULL YEAR NEGRONI🍹

BURDOCK (Arctium minus / Arctium lappa)
BURDOCK (Arctium minus / Arctium lappa)

Common Yarrow (Achillea millefolium)
Common Yarrow (Achillea millefolium)

Common Hogweed (best bits) & Giant Hogweed + Hybridisation
Common Hogweed (best bits) & Giant Hogweed + Hybridisation

👌🏻📅FLAVOUR FRED SUMMER ON TOAST📅👌🏻
👌🏻📅FLAVOUR FRED SUMMER ON TOAST📅👌🏻

🌹💐 DOG ROSE PETAL CHEONG 💐🌹
🌹💐 DOG ROSE PETAL CHEONG 💐🌹

🫙🍋ELDERFLOWER & PRESERVED LEMON PICKLED RADISHES & ELDERFLOWER SHRUB🍋🫙
🫙🍋ELDERFLOWER & PRESERVED LEMON PICKLED RADISHES & ELDERFLOWER SHRUB🍋🫙

🍍🌱PINEAPPLE WEED & ELDERFLOWER TEPACHE (+ friends) 🌱🍍
🍍🌱PINEAPPLE WEED & ELDERFLOWER TEPACHE (+ friends) 🌱🍍

🌱SWEET WOODRUFF 🌱 (Galium odoratum)
🌱SWEET WOODRUFF 🌱 (Galium odoratum)

PHEASANT BACK / DRYADS SADDLE – on the grill
PHEASANT BACK / DRYADS SADDLE – on the grill

Elderflower and why I love elder
Elderflower and why I love elder

♻️FULL ON FERMENTED SPRING MUSHROOM SEASONING♻️
♻️FULL ON FERMENTED SPRING MUSHROOM SEASONING♻️

Common Dandelion (Taraxacum officinale)
Common Dandelion (Taraxacum officinale)

🙏 MOREL & MAIPILZ KIEV 🙏 WITH WILD GARLIC PESTO Part 3 of 3
🙏 MOREL & MAIPILZ KIEV 🙏 WITH WILD GARLIC PESTO Part 3 of 3

🍽️🌱MAIPILZ / ST. GEORGE’S MUSHROOM 🫠👨🍳 MOREL & MAIPILZ KIEV: Part 2 of 3
🍽️🌱MAIPILZ / ST. GEORGE’S MUSHROOM 🫠👨🍳 MOREL & MAIPILZ KIEV: Part 2 of 3

💫💥THE BLACK MOREL💥💫 MOREL & MAIPILZ KIEV: Part 1 of 3
💫💥THE BLACK MOREL💥💫 MOREL & MAIPILZ KIEV: Part 1 of 3

☠️LILY-OF-THE-VALLEY☠️
☠️LILY-OF-THE-VALLEY☠️

BLUEBELLS
BLUEBELLS

🥂🌺Flowering Currant & Rhubarb Shrub🥂🌺
🥂🌺Flowering Currant & Rhubarb Shrub🥂🌺

🪵Oak Mazegill🪵
🪵Oak Mazegill🪵

🌱🧄WILD GARLIC MAYONNAISE 3 WAYS🧄🌱
🌱🧄WILD GARLIC MAYONNAISE 3 WAYS🧄🌱

🌱🍋🌶️ WILD LEAF CHERMOULA RECIPE🌶️🍋🌱
🌱🍋🌶️ WILD LEAF CHERMOULA RECIPE🌶️🍋🌱

🌱WILD GARLIC OIL🧄
🌱WILD GARLIC OIL🧄

🌱🤏🏼SAFE NETTLE TOP PICKING🤏🏼🌱
🌱🤏🏼SAFE NETTLE TOP PICKING🤏🏼🌱

🥢🍣PICKLED MAGNOLIA PETALS 🥢🍣
🥢🍣PICKLED MAGNOLIA PETALS 🥢🍣

🥢WILD TURNIP CAKE – FLAVOUR FRED STYLE🥢
🥢WILD TURNIP CAKE – FLAVOUR FRED STYLE🥢

☠️🪦 POISONOUS YEW TREE ☠️🪦 (Taxus baccata)
☠️🪦 POISONOUS YEW TREE ☠️🪦 (Taxus baccata)

🌈🍧 WILD LAYERED DESSERT 🌈🍧
🌈🍧 WILD LAYERED DESSERT 🌈🍧

NEW NETTLES & NETTLE CHALLAH
NEW NETTLES & NETTLE CHALLAH

VELVET SHANK vs ENOKITAKE
VELVET SHANK vs ENOKITAKE

LORDS & LADIES aka CUCKOOPINT / ADAM & EVE (Arum maculatum)
LORDS & LADIES aka CUCKOOPINT / ADAM & EVE (Arum maculatum)

JAPANESE QUINCE ♻️ ZERO WASTE ♻️ ORNAMENTAL FLAVOURS
JAPANESE QUINCE ♻️ ZERO WASTE ♻️ ORNAMENTAL FLAVOURS

Vacuum Distillation – Spring Leaf Liqueur “LIQUOR SILVARUM”
Vacuum Distillation – Spring Leaf Liqueur “LIQUOR SILVARUM”

🍄👕 MUSHROOM JUMPER 👕🍄 with @queer.as.funghi
🍄👕 MUSHROOM JUMPER 👕🍄 with @queer.as.funghi

🍫🍄🌶BIRCH POLYPORE CHAI CHOCOLATE FONDANT 🍫🍄🌶
🍫🍄🌶BIRCH POLYPORE CHAI CHOCOLATE FONDANT 🍫🍄🌶

NEW (Y)EAR JELLY JAFFAS
NEW (Y)EAR JELLY JAFFAS

OYSTER MUSHROOM JERKY RECIPE
OYSTER MUSHROOM JERKY RECIPE

♻️ KVASS USING BREAD CRUST, SOURDOUGH DISCARD, BEETROOT ♻️
♻️ KVASS USING BREAD CRUST, SOURDOUGH DISCARD, BEETROOT ♻️

🍔 FILTHY FORAGED MUSHROOM BURGER 🍔
🍔 FILTHY FORAGED MUSHROOM BURGER 🍔

🌲 NOBLE FIR MOLASSES 🌲
🌲 NOBLE FIR MOLASSES 🌲

CONFIT GARLIC RECIPE 🧄🧄
CONFIT GARLIC RECIPE 🧄🧄

MEDLAR STICKY TOFFEE PUDDING aka “TUDOR-ARSE FRUIT”
MEDLAR STICKY TOFFEE PUDDING aka “TUDOR-ARSE FRUIT”

ALBINO WEREWOLF MUSHROOM
ALBINO WEREWOLF MUSHROOM

Nettle Gnocchi
Nettle Gnocchi

Cézanne Exhibition at Tate Modern – “With an apple, I will astonish Paris”
Cézanne Exhibition at Tate Modern – “With an apple, I will astonish Paris”

Porcini, CEP, Steinpilz, Penny Bun (Boletus Edulis)
Porcini, CEP, Steinpilz, Penny Bun (Boletus Edulis)

Pine Bolete, Gozney Dome, Ezme @nomadicdinners
Pine Bolete, Gozney Dome, Ezme @nomadicdinners

🍄🍄 FLY AGARIC (Amanita Muscaria) 🍄🍄
🍄🍄 FLY AGARIC (Amanita Muscaria) 🍄🍄

PONTACK SAUCE – elderberry sauce dating back to 17th century
PONTACK SAUCE – elderberry sauce dating back to 17th century

The Wildest Bloody Mary
The Wildest Bloody Mary

Courgette Baba Ganoush
Courgette Baba Ganoush

Crunchiest pickled cucumbers
Crunchiest pickled cucumbers

Red Wine Pickled Blackberries
Red Wine Pickled Blackberries

Making Medieval Ink – Oak Galls
Making Medieval Ink – Oak Galls

Shiitake Inoculation
Shiitake Inoculation

Common Mallow 3 Ways
Common Mallow 3 Ways

Wild Garlic 3 Ways Part 1
Wild Garlic 3 Ways Part 1

Winter Mushroom Farewell Dinner
Winter Mushroom Farewell Dinner

Breaded Winter Chanterelle mushrooms: with tips on foraging, preserving & flavour


